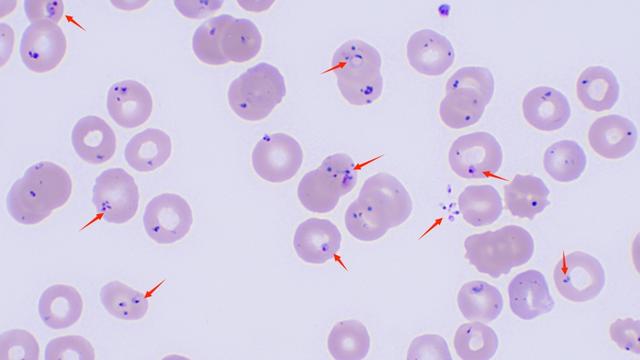

转自:上观新闻


淋巴瘤患者在治疗后一年内又出现反复发热和溶血性贫血症状,是肿瘤复发?还是新发自身免疫性疾病?
近日,上海市第一人民医院检验医学中心结合形态学和分子诊断技术,为一位反复发热贫血的淋巴瘤术后患者精准识别出致病元凶——微小巴贝虫,及时确定诊疗方向,避免误诊风险。
65岁的黄阿姨因患淋巴瘤接受了脾切除术和多次化疗。近日,黄阿姨又出现了反复发热、肌肉酸痛等流感样症状,担心肿瘤复发的她来到了市一医院血液科就诊。
入院后,黄阿姨被收治于血液科病区。血常规结果显示,她血液中红细胞、白细胞和血小板同时减少,出现溶血性贫血,初步怀疑可能是淋巴瘤所致。
市一医院检验医学中心医生许丹珺和谢晓玲检查黄阿姨血液报告时发现,其红细胞内存在异常内容物和环状体,这意味着有寄生虫存在。
考虑到黄阿姨近期并无疫区旅居史,唯一可能的暴露仅仅是一次户外露营。市一医院检验医学中心医生李胜南为她加做了铁染色和吉姆萨染色检查,并进行了疟原虫抗原检测。尽管疟原虫抗原检测阴性,但形态学团队敏锐识别出了“帕彭海默小体”和形态多样的虫体结构,包括典型的“马耳他十字”形态,这是巴贝虫特有的形态特征,为后续诊断提供了关键线索。
显微镜下的巴贝虫,可见其典型的“马耳他十字”形态。
形态学初筛初步锁定寄生虫感染方向后,还需要进一步精准诊断。面对罕见病原体,传统检测方法灵敏度不足、试剂可及性低。
市一医院检验医学中心启动分子诊断平台,利用病原微生物宏基因组二代测序技术,在24小时内明确了致病元凶——微小巴贝虫。这是一种主要通过蜱虫叮咬传播的寄生虫,可侵入红细胞,导致溶血性贫血、发热、黄疸甚至肾功能衰竭。对于健康人群而言,巴贝虫感染可能仅表现为轻微流感样症状,但对免疫力低下的患者则可能致命。
有了决定性诊断依据,黄阿姨从血液科转入感染科,治疗方案从抗肿瘤治疗转向抗寄生虫治疗,症状逐渐好转。
近年来,上海市一医院检验医学中心积极培养形态学人才梯队,深耕形态学平台建设,使传统技术在现代医学中持续焕发活力。同时,中心引进创新分子诊断技术,以分子平台覆盖广谱病原体,突破疑难感染诊断瓶颈,为临床疑难疾病诊断提供坚实支持。